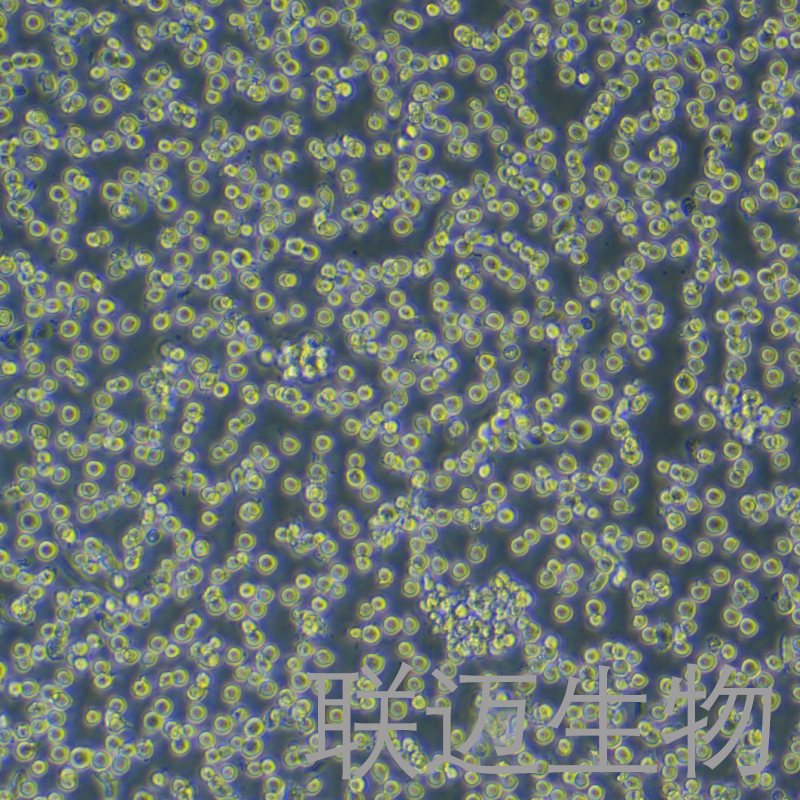
HEL细胞（红白细胞白血病细胞STR鉴定正确）LM8C0280

HEL细胞(红白细胞白血病细胞STR鉴定正确)LM8C0280
HEL
¥1500
1株
起订
上海 更新日期:2026-01-28
产品详情:
- 中文名称:
- HEL细胞(红白细胞白血病细胞STR鉴定正确)LM8C0280
- 英文名称:
- HEL
- 品牌:
- 联迈生物/LMAI Bio
- 产地:
- 中国/上海
- 保存条件:
- 常温
- 纯度规格:
- 99%
- 产品类别:
- 细胞系
- 种属:
- 人
- 组织:
- 外周血
- 细胞系:
- 正常细胞
- 细胞形态:
- 淋巴母细胞样
- 生长状态:
- 悬浮生长
- 冻存条件:
- 无血清冻存液,液氮储存
公司简介
上海联迈生物工程有限公司(LMAIBio)是一家经营生物、仪器、试剂、耗材等科研产品的研发以及销售一体的高科技生物公司,公司的服务和业务网络遍及全国,在同行获得一致好评。特别是生物试剂和细胞产品更是种类齐全、价格实惠,美国原装进口原代细胞,专业培养基,常用传统培养基,细胞培养用的相关试剂,氨基酸,抗生素,维他命类产品品种齐全,试剂耗材种类繁多。公司的规模和产品种类日益扩大和更新,我们一直秉承着代理良好的品牌产品,服务好每一位顾客,将好的科学技术和方法推荐顾客的服务宗旨为广大客户提供各类服务,产品、技术咨询。联迈生物(LMAIBio)不仅为客户提供“高质量的产品”,同时也提供“良好的
服务”,公司拥有一批基础知识扎实、产品知识丰富的销售人员,以及在生命科学领域经验丰富并且十分专业的技术支持团队,随时为客户提供技术咨询和售后服务。主营产品/服务:试剂盒:ELISA试剂盒、免疫组化试剂盒、分子生物学试剂盒、细胞凋亡试剂盒。细胞培养:血清,专业培养基,常用传统培养基。耗材:进口、国产细胞培养耗材、普通实验耗材。生化试剂:原装进口生化试剂、国产生化试剂。抗体:进口原装抗体、单克隆抗体、多克隆抗体、一抗、二抗等等。蛋白/抗原:重组蛋白,多肽合成,天然蛋白,细胞因子。
| 成立日期 | (9年) |
| 注册资本 | 100万人民币 |
| 员工人数 | 1-10人 |
| 年营业额 | ¥ 100万-300万 |
| 经营模式 | 贸易,工厂,试剂,定制,服务 |
| 主营行业 | 生化试剂,抗体,蛋白组学,分子生物学,细胞生物学 |
HEL细胞(红白细胞白血病细胞STR鉴定正确)LM8C0280相关厂家报价 更多
-

- HEL细胞|人红白细胞白血病细胞(提供Str鉴定报告)
- 上海弘顺生物科技有限公司 VIP
- 2026-04-05
- 询价
-

- HEL Cell|人红白细胞白血病细胞
- 上海冠导生物工程有限公司 VIP
- 2026-04-05
- 询价
-

- HEL Cells人红白细胞白血病细胞库专业复苏|有STR图谱
- 上海宾穗生物科技有限公司 VIP
- 2026-04-04
- 询价
-

- HEL(人红白细胞白血病细胞)
- 上海博尔森生物科技有限公司 VIP
- 2026-04-03
- ¥1700
-

- HEL人红白细胞白血病细胞
- 上海抚生实业有限公司 VIP
- 2026-04-03
- ¥1500
-

- HEL人白血病细胞
- 上海西格生物科技有限公司 VIP
- 2026-04-03
- ¥16800
-

- HEL(人红白细胞白血病细胞)
- 澳培赛生物科技(上海)有限公司 VIP
- 2026-04-03
- ¥1700
-

- HEL(人红白细胞白血病细胞)YB-71280HC
- 上海钰博生物科技有限公司 VIP
- 2026-03-26
- ¥1800
-

- 人红白细胞白血病细胞HEL(STR鉴定) | EnkiLife恩玑生命
- 武汉恩玑生命科技有限公司 VIP
- 2026-03-23
- 询价
-

- HEL人红白细胞白血病细胞
- 广州弗尔博生物科技有限公司
- 2026-02-04
- 询价